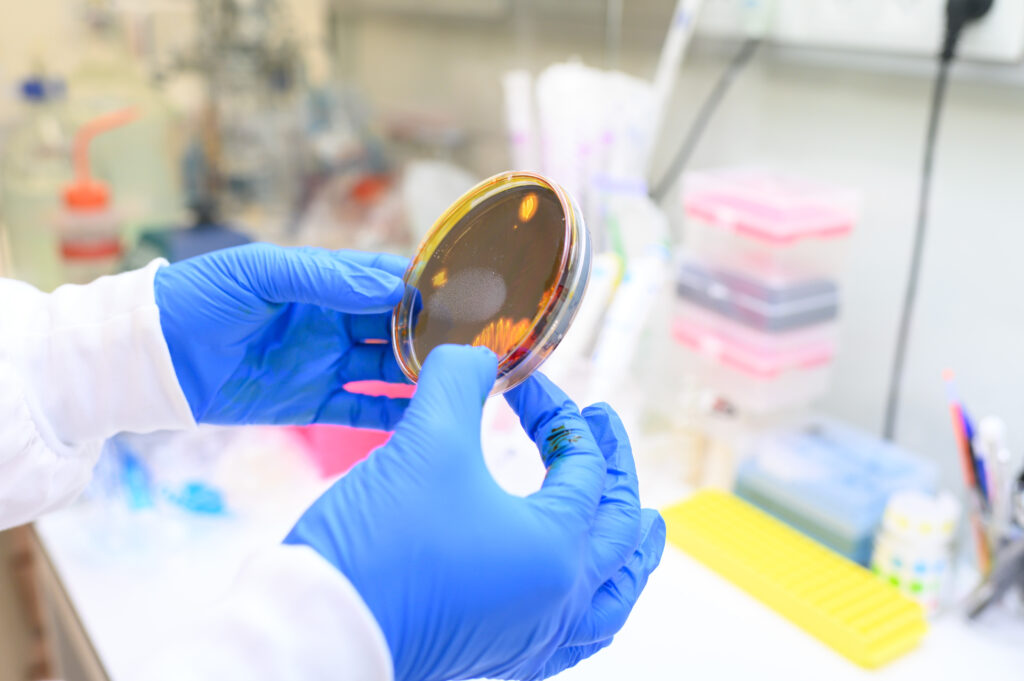

Vom Labor in die Versorgung: Wie Governance, Public-Private-Allianzen und internationale Ausrichtung Innovation wirksam machen.
Oder: Über Verantwortung, Transfer und Tempo im israelischen Gesundheits-Ökosystem – und was Europa daraus lernen könnte
Der erste Halt unserer Healthcare- & Medtech-Tour mit Fokus auf Innovation und Ökosysteme Anfang Februar 2026 findet im Untergeschoss vor einem Aufzug statt. Keine Präsentation, kein Konferenzraum, kein Begrüßungskaffee. Die Tür zur Notaufnahme des Tel Aviv Sourasky Medical Center öffnet sich, und mit ihr eine Frage, die sich hier nicht theoretisch stellt, sondern praktisch und mit aller Dringlichkeit: Was tun, wenn plötzlich hunderte schwerverletzte und multitraumatisierte Menschen gleichzeitig transportiert und interdisziplinär versorgt werden müssen?

Wenn nicht Stunden bleiben, sondern Minuten, mitunter nur 90 Sekunden. Wenn Informationen fragmentiert sind, Personal unter Hochdruck arbeitet und jede Entscheidung unmittelbare Folgen hat. Wenn von allem zu wenig da ist. Wenn alle zugleich informiert werden müssen. In der Notaufnahme von Dr. Eyal Hashavia, Leiter der Traumaversorgung am Ichilov, ist das kein Gedankenexperiment, sondern Realität. Hier entschied sich, während Patientinnen und Patienten bereits auf Tragen lagen, ob das Gesundheitssystem unter Extremdruck erstarrt – oder handlungsfähig bleibt und sich. Ob es sich und seine Abläufe anzupassen bereit ist, bereit also für Innovation.
„In der Notaufnahme gibt es keine Zeit für Pilotprojekte“, sagt Hashavia, der während dem Gespräch mit uns immer wieder auf dem Handy angerufen wird, um Entscheidungen zu treffen, die nicht warten können. „Wir sind hier bewusst flexibel in Bezug auf unsere Ressourcen und Vorschriften und schaffen dadurch Ad-hoc-Lösungen. Der Schwerpunkt meiner Tätigkeit liegt dabei auf der Entscheidungsfindung unter Unsicherheit.“ Der Satz fällt beiläufig, doch er beschreibt eine Haltung, welche die unterschiedlichen Elemente der israelischen Healthcare-Landschaft nährt und Forschung und Entwicklung, Versorgungsstrukturen und klinischen Alltag, Venture-Funds und Ministerien verbindet: Die Übersetzung in die Praxis unter komplexen Rahmenbedingungen ist kein nachgelagerter Schritt. Sie ist Voraussetzung.
Wissen zählt erst, wenn es wirkt
Israel gilt seit Jahren als Hotspot für medizinische Innovation. Doch der beeindruckendste Unterschied liegt nicht in der Zahl der Start-ups oder Patente sondern in der Art, wie schnell neues Wissen Teil des klinischen Alltags, der Versorgung von Patienten oder der Verringerung von unnötigen Wartezeiten bei Therapie-Entscheidungen, Diagnosen oder neuen Behandlungsmethoden wird. Forschung, Anwendung, Regulierung und Finanzierung sind enger miteinander verschränkt als in vielen europäischen Systemen. „Unser Kriterium ist nicht, ob eine Innovation existiert, sondern wie sehr sie uns im Klinikalltag weiterhilft“, bestätigt Prof. Eli Sprecher, CEO des Ichilov-Krankenhauses. Damit verschiebt sich der Innovationsbegriff: Erfolg misst sich nicht an Veröffentlichungen oder Förderzusagen, sondern an veränderten Abläufen auf Station, an messbar verbesserten, sprich effizienteren Strukturen, versorgten Patienten, verringerten Wartezeiten und Reibungsverlusten. Nicht zuletzt ein Kostenfaktor.
Was dabei oft übersehen wird: Viele dieser Strukturen entstehen nicht in strategischer Abgeschiedenheit, sondern aus und innerhalb akuter Überforderung. Als die Zahl der Verletzten sprunghaft anstieg, führte das im Ichilov nicht zu institutioneller Lähmung, sondern zu einer radikalen Überarbeitung der Versorgungsprozesse. Abläufe in der Notaufnahme wurden neu gedacht, Verantwortlichkeiten neu verteilt, Schnittstellen vereinfacht. Nicht im Sinne eines Masterplans, sondern anwendungsorientiert, kollaborativ und iterativ – gemeinsam mit denen, die unter Druck arbeiten mussten. Wie ist das möglich?
Daten als Treiber von Innovation
Ein zentraler Hebel dieser Übersetzung liegt in der konsequenten Nutzung von Daten. Am Ichilov ist mit I-NEXT eine Einheit entstanden, die klinische Daten systematisch zusammenführt und für Ärztinnen und Ärzte, Verwaltung und Pflege nutzbar macht. Es geht dabei weniger um futuristische KI-Visionen als um ganz praktische Fragen: Welche Information liegt wann vor? Und wer kann sie in einer Entscheidung gut gebrauchen? In Israel wird der Umgang mit Gesundheitsdaten stärker als infrastrukturelle Voraussetzung für Versorgung verstanden, während in Europa der Fokus traditionell stärker auf Datenschutz als Schutzraum liegt – zwei Perspektiven, die unterschiedliche Prioritäten setzen.

„Wir behandeln Daten nicht als Nebenprodukt der Medizin, sondern als klinische Infrastruktur“, erklärt Dr. Michal Shevach, COO von I-NEXT Data, dem krankenhausinternen Startup-Accelerator. „Wenn Daten sauber integriert sind, beschleunigt sich jede Entscheidung – und damit auch die Versorgung.“
Der Engpass ist hier selten die Technologie selbst. Er liegt in der Integration in bestehende Workflows – ein Problem, das auch europäischen Krankenhäusern vertraut ist.
Dass das Ichilov seine klinischen Daten kürzlich vollständig in die Cloud überführt hat, ist dabei mehr als ein technischer Schritt. Es ist ein bewusstes Bekenntnis zu Geschwindigkeit, Skalierbarkeit – und zu Risiko. In einem sicherheitssensiblen Umfeld gilt dies als Ausdruck einer Innovationskultur, die Risiken nicht verdrängt, sondern aktiv managt. Diese Bereitschaft, solche Risiken einzugehen, wirft mit Blick auf den stärker gesicherten Markt in Deutschland und Europa die Fragen nach Governance, Datenschutz und Verantwortung auf. Wer trägt die Haftung, wenn Systeme versagen, und wie transparent sind diese Entscheidungen für Personal, Patienten und Öffentlichkeit?
Innovation entsteht dort, wo Versorgung stattfindet
Auffällig ist, dass viele medizinische Innovationen in Israel innerhalb oder in enger Zusammenarbeit mit den Kliniken entstehen. Ärztinnen, Pflegekräfte und Forschende arbeiten gemeinsam an Lösungen für konkrete Probleme. „Innovation entsteht nicht außerhalb der Klinik und wird dann importiert“, sagt Prof. Omer Trivizki, Chief Medical Officer von I-NEXT. „Sie entsteht aus klinischen Problemen heraus – und bleibt so lange im Haus, bis sie den Alltag wirklich verbessert.“ Entscheidend sei dabei, so betont er, die Einbindung der Mitarbeitenden. Über I-NEXT organisiert das Ichilov regelmäßig Hackathons mit Ärztinnen, Pflegekräften und administrativem Personal. Ziel ist nicht technologische Spielerei, sondern Akzeptanz und Alltagstauglichkeit: Lösungen sollen den Klinikalltag einfacher, effizienter und patientenorientierter machen. Innovation wird hier nicht „eingeführt“, sondern gemeinsam entwickelt – ein wesentlicher Grund dafür, dass Veränderungen nicht blockiert, sondern getragen werden.

Psychische Gesundheit: Von der App zur Intervention
Besonders sichtbar wird dieser Pragmatismus im Bereich der mentalen Gesundheit. Mentale Gesundheit fällt in Israel mitnichten in den Bereich Lifestyle, sondern ist Teil der regulären medizinischen Versorgung. Aus Gründen. Nach den Anschlägen vom 7. Oktober 2023 und den folgenden Kriegsmonaten stieg der Bedarf an wirksamen Therapien sprunghaft. Der Markt sortierte sich neu, Schwerpunkte in Forschung und Entwicklung, in Finanzierung und Regulierungsprozessen verschob sich. GrayMatters Health, ein Unternehmen im Bereich Gesundheitstechnologie, das eine Suite für interventionelle Psychiatrie entwickelt und vermarktet, steht exemplarisch für die Weiterentwicklung von digitaler Mental-Health-Unterstützung hin zu klinisch integrierten evidenzbasierten Interventionen. Die Anwendungen, die auf fMRI-informierten EEG-Biomarkern basieren, wurden zu einem Medizinprodukt namens Prism. Prism hat bereits in vier Krankenhäusern in Israel und an der NYU Langone in den USA vollständige klinische FDA-Studien durchlaufen und wurde von der FDA für die Behandlung von PTBS zugelassen. Dies ist die einzige FDA-Zulassung zur Behandlung von PTBS, die in den letzten acht Jahren erteilt wurde, sei es für ein Medikament oder ein Medizinprodukt. Und so wird Prism bei Posttraumatischen Belastungsstörungen, Depressionen und weiteren Indikationen nicht als optionale Ergänzung eingesetzt, sondern eingebettet in bestehende Versorgungspfade.
„Der Gesundheitsmarkt ist sensibel, er toleriert keine Lösungen ohne klinische Evidenz, ohne Wirkungsnachweis bei den Betroffenen“, sagt Rani Cohen, Mitgründer von GrayMatters Health. „Das beschleunigt – existenziell, aber effektiv.“ Was nicht hilft, verschwindet schnell. Was wirkt, wird skaliert, die Krise fungiert hier als Katalysator für Reife und Einsatzbereitschaft. Möglich wird dies durch einen Ansatz, der Evidenz, Regulierung und Anwendbarkeit von Beginn an zusammendenkt und innerhalb des klinischen Alltags entsteht, nicht außerhalb.
Übrigens: In Israel ist der Zugang zu neuen Diagnose- und Therapieangeboten schneller und selbstversändlicher Bestandteil der gesetzlichen Versorgung: Leistungen, die sich als wirksam bewähren, werden über die Krankenkassen und klinischen Netzwerke breit verfügbar gemacht. Diese strukturelle Integration verkürzt die Zeit vom Proof of Concept bis zur flächendeckenden Anwendung – unabhängig davon, ob es sich um digitale Tools, neue Behandlungspfade oder präventive Angebote handelt. Dabei fließen Patient:innen- und Praxiserfahrungen vergleichsweise früh in die Entwicklung und Anpassung neuer Versorgungsangebote ein, weil klinische Studien, Krankenkassen und Versorgungspartner eng miteinander verzahnt sind. Diese Rückkopplung stärkt nicht nur die Alltagstauglichkeit neuer Anwendungen, sondern unterstützt auch ihre Akzeptanz im Versorgungssystem.
In Deutschland wird der Zugang zu neuen digitalen und therapeutischen Leistungen häufig durch Regulierungs- und Erstattungsprozesse determiniert, die Zeit und institutionelle Abstimmung erfordern. Die Einführung von DiGA-Verfahren und der elektronischen Patientenakte markieren Fortschritte, doch bleibt die Herausforderung, Innovationen schneller als Ergänzung zur Routineversorgung verfügbar zu machen. Patient:innenbeteiligung ist hier auf verschiedenen Ebenen institutionalisiert, etwa in Patientenbeiräten, in Sicherstellungsausschüssen oder bei der Entwicklung von DiGA-Regelungen. Gleichzeitig wird von Expert:innen immer wieder betont, dass mehr systematische Einbindung von Patientenerfahrungen in Gesundheits- und Sicherheitsprozesse notwendig ist, um Vertrauen und Wirksamkeit zu steigern.
Grundlagenforschung als Ausgangspunkt – Translationale Forschung als eigene Disziplin
Auch an den großen Forschungsinstituten ist diese Logik präsent. „Zwischen Entdeckung und Anwendung liegt das oft stiefmütterlich beackerte Feld der „Übersetzung““, definiert Dr. Sharon Fireman, Leiterin der Innovations- und Transfereinheit BINA ihren Aufgabenbereich. Am Weizmann Institute of Science existieren seit einigen Jahren eigene Einheit, die sich ausschließlich mit der Überführung von Grundlagenforschung in Anwendung beschäftigen. Das BINA (Bridge Innovation Nurture Advance) trägt das „nurture“= Fördern/Nähren nicht ohne Grund im Namen. Die Überführung von Forschungsergebnissen in die Anwendung ist hier die zentrale Aufgabe – mit klaren Zuständigkeiten, Budgets und Ressourcen, und nicht zuletzt Verantwortung und verbindlichen Erfolgskriterien.
Der beständige Erfolg dieses Übersetzungsprozesses beruht auch auf seiner engen Verbindung zu exzellenter Grundlagenforschung. „Das Genom liefert den Bauplan, aber Proteine sind die funktionellen Einheiten in unseren Zellen. Wenn wir verstehen, wie sich diese ‚Arbeiter‘ bei verschiedenen Krankheiten verändern oder funktionsunfähig werden, können wir präziser eingreifen – anstatt nur die Symptome zu behandeln.“ Dies wurde besonders deutlich am Weizmann Institute of Science während eines morgendlichen Gesprächs mit Prof. Yifat Merbl, einer der führenden Proteomik-Forscherinnen des Landes. Ihre Arbeit beginnt dort, wo das medizinische Verständnis oft an seine Grenzen stößt: bei der Frage, was tatsächlich in der Zelle geschieht, nachdem die genetische Information übersetzt wurde.
Merbls Forschung zur Proteinstabilität und -modifikation ist hochkomplex und langfristig angelegt – dennoch ist sie von Anfang an anwendungsorientiert. Dies wird ermöglicht, indem sowohl die Entwicklung von Plattformtechnologien als auch deren Nutzung für Fragen ungedeckter klinischer Bedürfnisse als erster Schritt in einem längeren Translationsprozess integriert werden. Dieser integrierte Ansatz mit einer engen Verbindung zu klinischen Fragen, Translationseinheiten und potenziellen Industriepartnern ist erforderlich, damit selbst hochgradig abstraktes Wissen frühzeitig in einen Anwendungskontext eingebettet werden kann, ohne dabei an wissenschaftlicher Tiefe einzubüßen. Und so erklärt uns Prof. Merbl, dass sie in Jeans und Turnschuhen dasitzt, weil sie kurz davor ist, mit einem Start-up, das aus ihrem Labor hervorgegangen ist, Promise Bio, auf Exkursion zu gehen, das eine ihrer wissenschaftlichen Entdeckungen in eine reale Anwendung umsetzt.
Israel Innovation Authority: Rückgrat der public-private Kollaboration
Überhaupt ist die enge Verschränkung öffentlicher und privater Finanzierung ein zentrales Merkmal des israelischen Ökosystems. Aufwändige Grundlagenforschung und kostenintensive Produktentwicklung im kleinteiligen medizinischen Bereich wären ohne dieses Zusammenspiel kaum möglich. Staatliche Autoritäten reduzieren Risiken in frühen Phasen und später das Ausräumen von Hemmschwellen bei der Markteinführung, private Investoren und multinationale Unternehmen – viele mit eigenen R&D-Zentren im Land – übernehmen Skalierung und Marktzugang. Innovation wird so zu einer gemeinsamen Aufgabe, nicht zu einem Entweder-oder.
In Israel äußert sich das staatliche Commitment weniger in Leitbildern und Koalitionsverhandlungen als in finanziellen Zusagen und der Schaffung von Rahmenbedingungen – und in deren Verlässlichkeit. Förderungen sind großzügig, mehrjährig und darauf ausgelegt, Risiken mitzutragen. Eine tragende Rolle spielt dabei die Israel Innovation Authority (IIA). Sie fungiert nicht nur als Fördergeber, sondern als strategischer Orchestrator des gesamten Innovationssystems. Ihr Mandat reicht von der Finanzierung risikoreicher Grundlagenforschung über die Unterstützung junger Unternehmen bis hin zur Skalierung marktreifer Technologien.
Charakteristisch ist dabei weniger die Höhe einzelner Fördersummen als deren Robustheit. Zusagen sind darauf ausgelegt, Unsicherheit mitzutragen. Planungssicherheit entsteht nicht durch Ankündigungen, sondern durch Verbindlichkeit. Der Staat tritt geschlossen auf – über Ministerien, Programme und Institutionen hinweg – und übernimmt Ownership entlang des gesamten Prozesses: von der Forschung über die Erprobung bis zur Anwendung. Verantwortung wird nicht delegiert, sondern aktiv mitgetragen und durchgesetzt. Natürlich lassen sich Entscheidungen zentraler und schneller treffen, als es in europäischen Systemen mit stärkerer föderaler und demokratischer Aushandlung möglich wäre – was Effizienz erhöht, aber Beteiligung und Transparenz potenziell begrenzt. Die Kompromisslosigkeit und Geschwindigkeit hat jedoch auch ihren Preis.
Aber, so führt Shai Melcer aus, als Leiter des Nationalen Bio-Convergence-Programms verantwortlich für die Innovationsförderung im biotechnologischen Bereich staatliche Engagement über Institutions- und Sektorengrenzen hinweg als wirtschaftliche Notwendigkeit, „da der israelische Markt klein ist, muss jede relevante Innovation international gedacht werden. Innovation ist in Israel kein Add-on, sondern ein zentraler Wirtschaftsfaktor, sie sichert Produktivität, Exporte und Resilienz – gerade in einem Land mit begrenzten natürlichen Ressourcen.“ Unterstützt wird dies über ein robustes Netzwerk von Technologietransferstellen (TTOs), die eng mit führenden Universitäten und Forschungsinstituten verbunden sind und die Kommerzialisierung akademischer Forschung zum Ziel haben. Zu den wichtigsten TTOs gehören Yissum (Hebräische Universität), Ramot (Universität Tel Aviv), T3 (Technion) und Yeda (Weizmann-Institut), die Patente, Lizenzen und die Gründung von Start-ups in verschiedenen Branchen verwalten.

Wie komplex das Zusammenspiel der Institutionen ist, zeigt auch der Blick auf die nationale Blood Bank von Magen David Adom. Sie ist nicht nur Versorgungseinheit und stellt medizinische Infrastruktur, sie ist gleichzeitig ein zivilgesellschaftliches Projekt. Staatliche Finanzierung, private Spenden, Beiträge multinationaler Partner und ein breites ehrenamtliches Engagement greifen hier ineinander. Die Versorgungssicherheit basiert auf technologischer Exzellenz ebenso wie auf der aktiven Einbindung der Bevölkerung, als Blutspender, als einer der über 35.000 Ehrenamtlichen oder als private Finanziers – ein Beispiel auch dafür, wie tief das Gesundheitssystem und die Verantwortung für seinen Erhalt in der Gesellschaft verankert ist.
Der europäische Blick – Innovation verlangt Übersetzung als Systemleistung
Nicht erst an dieser Stelle drängt sich der Vergleich mit Europa auf – doch er verlangt nach Differenzierung. Nicht alles, was in Israel funktioniert, ist übertragbar. Die eigentliche Lernfrage lautet daher nicht, warum ein System schneller erscheint als das andere, sondern welche strukturellen Voraussetzungen Übersetzung ermöglichen – und welche sie blockieren, unabhängig von Mentalität oder kulturellem Selbstbild.
Europa ist kein homogener Markt, sondern ein Geflecht nationaler Gesundheitssysteme innerhalb eines gemeinsamen regulatorischen und förderpolitischen Rahmens. Die Europäische Union schafft mit verbindlichen Standards und Programmen wie Horizon Europe wichtige Voraussetzungen für Kooperation und wissenschaftliche Exzellenz. Zugleich ist dieser Rahmen komplex, rechtlich anspruchsvoll und konsensorientiert. Diese Eigenschaften sichern Stabilität und Rechtsklarheit, verlangsamen jedoch häufig die Überführung von Forschungsergebnissen in breit implementierte Versorgung.
Deutschland nimmt innerhalb dieses Gefüges eine besondere Rolle ein. Als größter europäischer Gesundheitsmarkt verfügt es über enorme Versorgungskapazitäten, eine starke industrielle Basis und international anerkannte Forschung. Gleichzeitig ist das System stark fragmentiert: Zuständigkeiten verteilen sich auf verschiedene Ebenen, Entscheidungswege sind lang, und Verantwortung entlang der Innovationskette bleibt selten klar gebündelt. Innovation entsteht durchaus, doch sie verharrt häufig in Projekten, Pilotphasen oder regional begrenzten Lösungen, statt systematisch skaliert zu werden.

Israel operiert unter anderen strukturellen Bedingungen. Der heimische Markt ist klein, nationale Skalierungsmöglichkeiten sind begrenzt. Gerade deshalb ist das System von Beginn an international ausgerichtet. Forschung, Produktentwicklung und klinische Erprobung werden konsequent auf Anschlussfähigkeit an den US-amerikanischen Markt ebenso wie an europäische Regulierung hin entwickelt. Internationale Zulassungsfähigkeit ist kein nachgelagerter Schritt, sondern integraler Bestandteil von Entwicklung, Finanzierung und strategischer Planung. Diese globale Orientierung wirkt als zusätzlicher Beschleuniger: Evidenz muss früh belastbar sein, regulatorische Strategien werden von Anfang an mitgedacht, und Skalierung ist systemischer Bestandteil des Innovationsprozesses.
Hinzu kommt eine enge Verzahnung öffentlicher und privater Finanzierung. Staatliche Förderprogramme reduzieren Risiken in frühen Phasen, private Investoren und multinationale Unternehmen mit eigenen Forschungs- und Entwicklungsstrukturen übernehmen Skalierung und Marktzugang. Aufwändige Grundlagenforschung und kostspielige Produktentwicklung im hochspezialisierten medizinischen Bereich werden arbeitsteilig getragen. Risiken werden verteilt, Verantwortung jedoch nicht verwässert, sondern institutionell abgesichert.
Israel zeigt damit kein Modell, das sich kopieren ließe. Zu unterschiedlich sind institutionelle, rechtliche und gesellschaftliche Rahmenbedingungen. Übertragbar ist jedoch die strukturelle Einsicht: Wissen wird nicht automatisch wirksam. Übersetzung ist kein Nebenprodukt wissenschaftlicher Exzellenz, sondern eine bewusst zu gestaltende Systemleistung – sie verlangt klare Zuständigkeiten, verlässliches Commitment und durchgängige Verantwortungsübernahme entlang der gesamten Innovationskette.
Wo Governance, Ökonomie und institutionelle Architektur zusammengedacht werden, entsteht Wirkung. Wo sie getrennt bleiben, bleibt Innovation Fragment. Aus dieser Perspektive betrachtet Brands & Places Innovation weniger als Ereignis denn als Strukturfrage – als Zusammenspiel von Verantwortung, Finanzierung und internationaler Anschlussfähigkeit: Wer Wirkung will, muss die Strukturen gestalten, in denen Wissen zirkuliert, entschieden und angewendet wird. Und hier setzt die Arbeit von Brands & Places an: nicht bei der Idee, sondern bei den Bedingungen ihrer Wirksamkeit und der Gestaltung des entsprechenden Ökosystems unter Einbindung der Stake-Holder.
Disclaimer: Die Autorin war auf Einladung des Jerusalem Press Club im Februar 2026 in Tel Aviv.